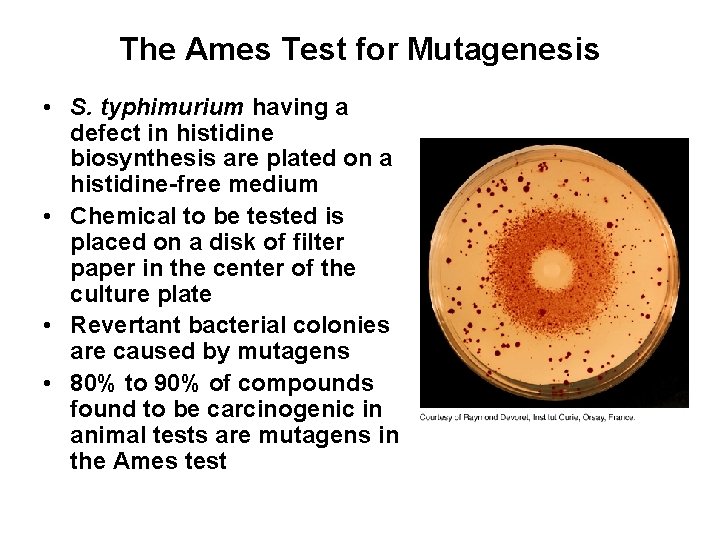
The Ames Test for Mutagenesis • S. typhimurium having a defect in histidine biosynthesis

Mutation A mutation is a change in the

- Slides: 58
Mutation A mutation is a change in the normal base pair sequence מוטציה – השתנות ברצף הנורמאלי של זיווגי הבסיסים Commonly used to define DNA sequence changes that alter protein function
Mutation ● DNA replication is extremely accurate, BUT… – Errors in polymerization occur – מוטציות במהלך הרפליקציה – Environmental factors, such as chemicals and ultraviolet radiation, can alter DNA – מוטציות כתוצאה מגורמים סביבתיים ● ● ● Irreversible changes to the cellular DNA can be lethal שינויים לא הפיכים יכולים להיות קטלנים Non-lethal changes can cause a heritable alteration of the genetic information, called a mutation Genetic changes are more noticeable in germ line cells than in somatic cells Systems exist for the repair of damaged DNA
A human DNA repair defect: Xeroderma pigmentosum Multiple skin cancers due to unrepaired UV damage to DNA
A human DNA repair defect: Bloom's syndrome
Spontaneous mutagenesis and errors in DNA replication ● ● DNA replication must accurately replicate 6 x 109 base pairs every time a human cell divides – בכל חלוקת תא יש להכפיל שישה טרליון נוקלאוטדים In man we see one new mutation per gene per 100, 000 cells per cell cycle. (spontaneous mutation frequency) –. באדם מוטציה אחת בכל מאה אלף חלוקות תא i. e. 1 error per 1010 bp incorporated
DNA polymerases have two main methods for ensuring accuracy: (a) Base selection Only AT and GC base pairs fit properly in the active site of the polymerase (b) Proofreading If a wrong base is inserted, then it is removed and replaced with the correct one before the next one is added
Induced mutagenesis Can be caused by environmental agents that damage DNA: • UV light • X-rays and g-rays • Chemical carcinogens e. g. cigarette smoke DNA damage can lead to mutations unless it is removed by DNA repair enzymes Unrepaired damage can have serious consequences
Somatic vs. germ line mutations • Somatic ( )גוף mutations can lead to cancer • Germ ( ראשוני / )נבט line mutations can lead to birth defects ( )מום מולד • Most mutations cause neither – Some fall in non-coding DNA – Others are silent רוב המוטציות אינן גורמות למחלות מכיוון שאינן פוגעות גני או - בנוקלאוטיד המעורב בתהליך התבטאות הגנים )אינטר ( אינטרונים
Natural causes of mutations מוטציות שנגרמות ע"י גורם טבעי • Base tautomerization – שינויים טאוטומרים • UV damage – נזקי קרינה • Spontaneous deamination דאמינציות
UV Radiation and Pyrimidine Dimers • UV radiation (200 -300 nm) induces the formation of dimers between adjacent thymine residues • Cytosine-cytosine and thymine-cytosine dimers occur less frequently • These pyrimidine dimers disrupt the structure of the double helix, blocking replication until the lesion is repaired
Mutations and Cancer • Mutations that affect nonessential DNA or that have negligible effects on a gene’s function are called silent mutations • Many mutations are detrimental, and a correlation exists between the accumulation of mutations and cancer • New chemicals, such as pharmaceuticals, must be tested for carcinogenic potential • Standard animal tests for carcinogenesis are lengthy and expensive • The simple Ames test measures the potential of a given chemical to promote mutations in a specialized bacterial strain
The Ames Test for Mutagenesis • S. typhimurium having a defect in histidine biosynthesis are plated on a histidine-free medium • Chemical to be tested is placed on a disk of filter paper in the center of the culture plate • Revertant bacterial colonies are caused by mutagens • 80% to 90% of compounds found to be carcinogenic in animal tests are mutagens in the Ames test
Intercalating Agents • Intercalating agents slip in between stacked base pairs • Distance between base pairs is doubled by an intercalating agent • Insertions or deletions of one or more nucleotides can occur during the replication of such distorted DNA
Chemical Mutagens • Classes of damage produced by chemical mutagens – Point mutations: one base pair is replaced by another – Insertions or deletions: one or more nucleotide pairs are inserted in or deleted from DNA • Important types of chemical mutagens – Alkylating agents אלקילציות – Deaminating agents דיאמינציות – Intercalating agents אינטרקלציות
Deamination of Cytosine - דאמינציה About 3% of the cytosine residues are methylated (intentionally). • Nitrous acid can be formed from nitrite and nitrate salts • Nitrous acid oxidatively deaminates aromatic amines • Cytosine is converted to uracil upon treatment with nitrous acid, causing a GC to AT transition • Cytosine sometimes spontanteously deaminates to uracil, indicating why DNA contains thymine rather than uracil קבוצת אמין
באחת מתאי הבת תהיה מוטציה נקודתית "התיקון" ע"י BER About 50% of the time the G is “corrected” to A resulting in a mutation
Alkylating Agents אלקילציות • Alkylating agents such as dimethyl sulfate are electrophiles • Such agents react most often with the nucleophilic N 7 position of the guanine base • Alkylation at N 7 can generate an apurinic site in DNA • Point mutations occur when guanine is replaced by another base • DNA methylation can be useful BER התיקון ע"י
Chemical mutagens סיכום – כימיקלים שגורמים למוטציות • Chemicals that accelerate the deamidation reaction – מאיצים דיאמינציה • Base analogues – אנלוגים לבסיסים • Alkylating agents – מבצעים אלקילציה • Intercalation agents - אינטרקלטורים
Overview of DNA repair pathways A. Base excision repair • B. Nucleotide excision repair. • C. Mismatch repair • D. Double-strand break repair by • homologous recombination. • E. Double-strand break by end joining •
Three general types of DNA repair pathways: 1) Direct Repair 2) Base excision Repair 3) Nucleotide excision repair Direct repair
Base excision repair
uvr. AB recognize the unpair bases
Mismatch repair
What happens when mismatch ? repair fails in humans • Missing enzymes homologous to Mut. S and Mut. L • Patients usually die by age 30 • Disease: hereditary nonpolyposis colorectal ( )מעי גס cancer (HPCC) • 1 in 200 people affected
Homologous End-Joining recovers information from the homologous chromosome Information lost A Crossing over Information restored
Overview of DNA repair pathways A. Base excision repair • B. Nucleotide excision repair. • C. Mismatch repair • D. Double-strand break repair by • homologous recombination. • E. Double-strand break by end joining •
SOS repair